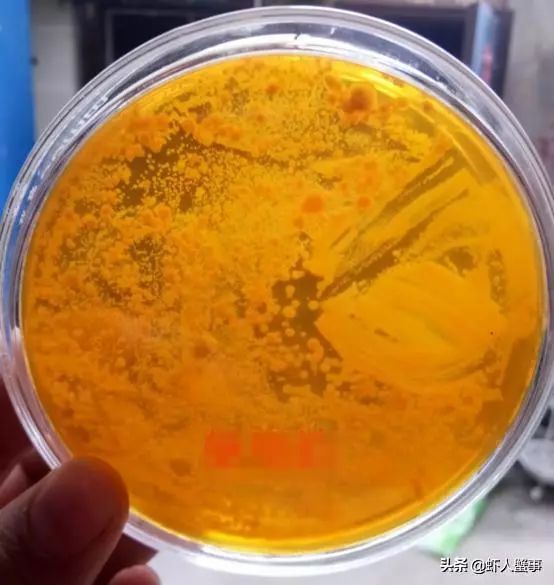
小龙虾养殖务必要小心池塘里的弧菌!否则雨后天晴就死虾!
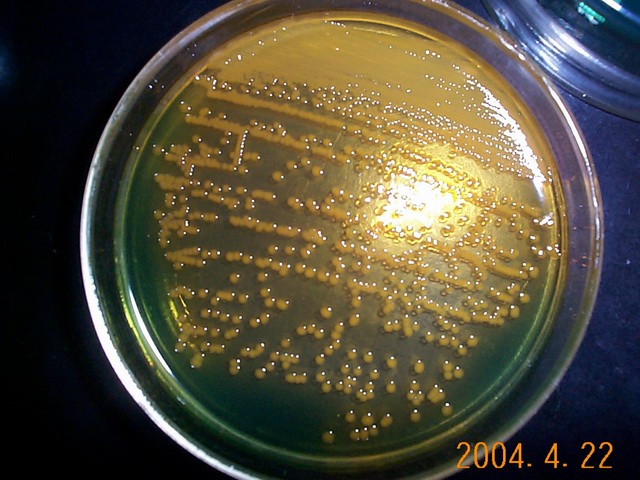
biological pollution of water bodies

麦氏弧菌

珍爱生命,远离毒品,说说fgo中的"瘾君子"英灵
图片尺寸640x651
麦角真菌01
图片尺寸1200x900
c10 弧菌属ppt
图片尺寸1080x810
对虾养殖最常见的三种弧菌你知道是什么吗?
图片尺寸1080x1159
抗生素和中草药在对虾弧菌病中的抑制作用
图片尺寸891x892
小龙虾养殖务必要小心池塘里的弧菌!否则雨后天晴就死虾!
图片尺寸554x585
史上最全弧菌预防方案小龙虾养殖户必读
图片尺寸1080x1920
弧菌知识360度详解不容错过
图片尺寸640x422
关于南美白对虾弧菌超标问题
图片尺寸2000x2667
注意啦弧菌爆发不同弧菌引发的疾病不同应对措施你得知道
图片尺寸1080x1439
biological pollution of water bodies
图片尺寸640x480
霍乱需要隔离吗_霍乱弧菌_致病菌
图片尺寸600x375
弧菌怎么治论坛网友有话说
图片尺寸302x268
南美白对虾弧菌如何防控?这有预防小妙招!
图片尺寸582x455
细菌的一些漂亮图片
图片尺寸500x400
关于图中所示霍乱弧菌的特点,下列哪项是错误的
图片尺寸322x247
谈"弧菌"色变,但是至今你还没有见过它长什么样子
图片尺寸1280x1275
第11章 弧菌属ppt
图片尺寸1080x810
令养殖户一直头疼的有害菌——弧菌,到底该如何搞定
图片尺寸640x594
霍乱弧菌 图片来源于网络
图片尺寸457x258